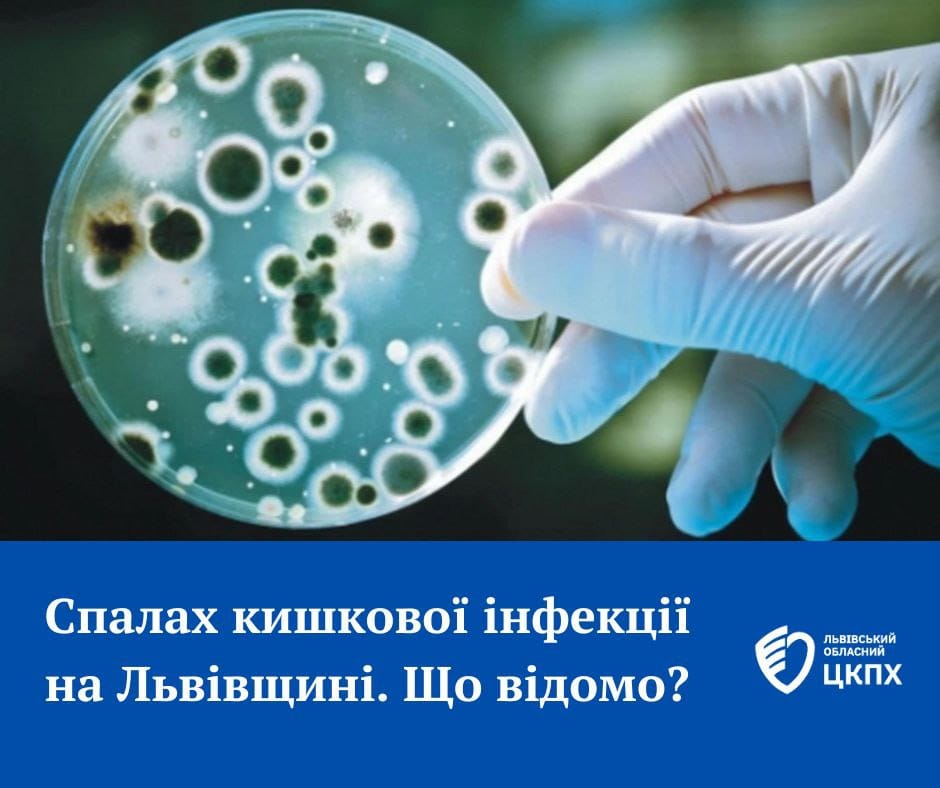

Триває епідрозслідування спалаху кишкової інфекції на Львівщині
28 червня 2024
Станом на сьогодні, 28 червня, зареєстровано 25 хворих.
У стаціонарі залишається 24 дитини. Стан усіх з позитивною динамікою.
Тривають лабораторні дослідження води, харчових продуктів та матеріалу від хворих. Епідрозслідування продовжується.




